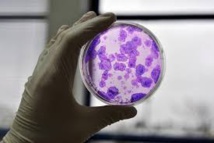
USA: 570 cliniques proposent des soins non-autorisés avec des cellules souches USA: 570 cliniques proposent des soins non-autorisés avec des cellules souches

Washington, Etats-Unis | AFP | jeudi 30/06/2016 - Quelque 570 cliniques aux Etats-Unis proposent des soins basés sur des cellules souches qui n'ont pas été autorisés par l'Agence américaine des médicaments, la FDA, ont déterminé des chercheurs dont l'étude est publiée jeudi.
Plus de 350 entreprises sur le territoire américain leur vendent directement ces soins qui peuvent présenter des dangers, révèle l'enquête dont les résultats paraissent dans la revue Cell Stem Cell.
La Californie est l'Etat où le plus de cliniques vendent ces traitements, dont 18 à Beverly Hills, le quartier chic de Los Angeles. Les chercheurs en dénombrent 104 en Floride, 71 au Texas et 21 dans la ville de New York.
Pour 61% des procédures proposées en clinique, les cellules souches sont dérivées de la graisse et pour 48% des cliniques, elles proviennent de la moelle osseuse, selon les fournisseurs.
Seulement 1% utilisent des cellules souches pluripotentes fabriquées en laboratoire à partir de cellules adultes et une seule clinique propose des cellules souches embryonnaires.
"Ce marché explose devant nos yeux et je ne pense pas qu'on était conscient de son étendue et de sa taille", note Leigh Turner, co-auteur et membre du Centre de bioéthique de l'université de Minnesota.
"Des réglementations devraient exister pour ce marché et on peut s'interroger sur le fait de savoir comment cette activité a pu connaître un tel essor aux Etats-Unis où des traitements basés sur les cellules souches et les instruments médicaux qui les produisent sont supposés être réglementés par les autorités, dont notamment la FDA", s'interroge-t-il.
Une porte-parole de la FDA, Andrea Fischer, a indiqué dans un courriel à l'AFP que "l'Agence est préoccupée par le fait que l'espoir suscité chez des patients par des traitements dont la sûreté et l'efficacité restent à démontrer pourrait les rendre vulnérables à des sociétés ou individus sans scrupule, fournisseurs de soins contenant des cellules souches qui sont illégaux et potentiellement dangereux".
L'Agence enjoint également "les personnes qui envisagent une thérapie avec des cellules souches de s'assurer qu'elles ont été approuvées par l'agence ou vont faire l'objet d'un essai clinique réglementé par la FDA".
La FDA précise enfin qu'elle va organiser en septembre deux réunions publiques sur les cellules souches et les tissus humains ainsi que sur les produits et traitements qui en sont dérivés.
Les sociétés font la promotion de ces traitements, qui restent expérimentaux, pour des blessures orthopédiques, de la moelle épinière, des troubles neurologiques, pulmonaires ainsi que pour des maladies cardiaques et même pour des interventions cosmétiques, ont expliqué les auteurs de l'étude publiée jeudi.
Selon eux, ce phénomène pourrait avoir un impact négatif auprès du public concernant la recherche sur les cellules souches, dont le potentiel médical est jugé prometteur pour régénérer des tissus et des organes, ou encore pour traiter des cancers.
"Dans quasiment tous les Etats (...) il est possible d'avoir accès localement à ces thérapies" et il n'est plus nécessaire pour les Américains d'aller par exemple au Mexique, a déterminé Paul Knoepfler, chercheur à l'université de Californie et principal co-auteur.
"Cela traduit un changement par rapport au tourisme médical typique en quête de soins avec des cellules souches" observé précédemment, souligne-t-il.
Pour Paul Knoepfler et Leigh Turner, leurs travaux devraient servir de base pour de futures études sur les entreprises qui se livrent à de la promotion commerciale directe des thérapies avec des cellules souches.
js/elc
© 1994-2016 Agence France-Presse
Plus de 350 entreprises sur le territoire américain leur vendent directement ces soins qui peuvent présenter des dangers, révèle l'enquête dont les résultats paraissent dans la revue Cell Stem Cell.
La Californie est l'Etat où le plus de cliniques vendent ces traitements, dont 18 à Beverly Hills, le quartier chic de Los Angeles. Les chercheurs en dénombrent 104 en Floride, 71 au Texas et 21 dans la ville de New York.
Pour 61% des procédures proposées en clinique, les cellules souches sont dérivées de la graisse et pour 48% des cliniques, elles proviennent de la moelle osseuse, selon les fournisseurs.
Seulement 1% utilisent des cellules souches pluripotentes fabriquées en laboratoire à partir de cellules adultes et une seule clinique propose des cellules souches embryonnaires.
"Ce marché explose devant nos yeux et je ne pense pas qu'on était conscient de son étendue et de sa taille", note Leigh Turner, co-auteur et membre du Centre de bioéthique de l'université de Minnesota.
"Des réglementations devraient exister pour ce marché et on peut s'interroger sur le fait de savoir comment cette activité a pu connaître un tel essor aux Etats-Unis où des traitements basés sur les cellules souches et les instruments médicaux qui les produisent sont supposés être réglementés par les autorités, dont notamment la FDA", s'interroge-t-il.
Une porte-parole de la FDA, Andrea Fischer, a indiqué dans un courriel à l'AFP que "l'Agence est préoccupée par le fait que l'espoir suscité chez des patients par des traitements dont la sûreté et l'efficacité restent à démontrer pourrait les rendre vulnérables à des sociétés ou individus sans scrupule, fournisseurs de soins contenant des cellules souches qui sont illégaux et potentiellement dangereux".
L'Agence enjoint également "les personnes qui envisagent une thérapie avec des cellules souches de s'assurer qu'elles ont été approuvées par l'agence ou vont faire l'objet d'un essai clinique réglementé par la FDA".
La FDA précise enfin qu'elle va organiser en septembre deux réunions publiques sur les cellules souches et les tissus humains ainsi que sur les produits et traitements qui en sont dérivés.
Les sociétés font la promotion de ces traitements, qui restent expérimentaux, pour des blessures orthopédiques, de la moelle épinière, des troubles neurologiques, pulmonaires ainsi que pour des maladies cardiaques et même pour des interventions cosmétiques, ont expliqué les auteurs de l'étude publiée jeudi.
Selon eux, ce phénomène pourrait avoir un impact négatif auprès du public concernant la recherche sur les cellules souches, dont le potentiel médical est jugé prometteur pour régénérer des tissus et des organes, ou encore pour traiter des cancers.
"Dans quasiment tous les Etats (...) il est possible d'avoir accès localement à ces thérapies" et il n'est plus nécessaire pour les Américains d'aller par exemple au Mexique, a déterminé Paul Knoepfler, chercheur à l'université de Californie et principal co-auteur.
"Cela traduit un changement par rapport au tourisme médical typique en quête de soins avec des cellules souches" observé précédemment, souligne-t-il.
Pour Paul Knoepfler et Leigh Turner, leurs travaux devraient servir de base pour de futures études sur les entreprises qui se livrent à de la promotion commerciale directe des thérapies avec des cellules souches.
js/elc
© 1994-2016 Agence France-Presse